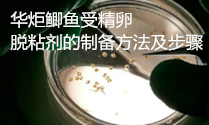

一种鲫鱼受精卵脱粘剂的制备方法及步骤
鲫鱼俗称鲫瓜子,肉味鲜美,肉质细嫩,它营养全面,含蛋白质多,脂肪少,食之鲜而不腻,能够增强抗病能力,防治心脑血管疾病,通乳汁,明目益智,美容抗皱。鲫鱼人工繁殖过程中,精卵细胞受精完成后,要加入脱粘剂使受精卵脱粘,能够增加受精卵和孵化率,目前市场上的脱粘剂主要是黄泥、滑石粉和食盐水,脱粘时间太长,影响孵化率,因此需要一种新的鲫鱼受精卵脱粘剂。
华炬新产品研究所技术咨询委员会科研人员现推荐一项一种鲫鱼受精卵脱粘剂的制备方法及步骤,该技术的优点是:该技术提供的一种鲫鱼受精卵脱粘剂,方法简单,鲫鱼的受精率为89%,孵化率为92%,成活率为87%,经济收入提高11.7%;原料丰富,营养均匀,红薯淀粉烘烤后进行糊化,再经面包酵母发酵,手感爽滑,加水后的溶液能够使使受精卵初步脱粘,又加入硫酸亚铁和碳酸氢铵,可以加速脱粘进行,使时间缩短为2~3分钟,明显提高工作效率;加入多种中药提取剂,既能提供营养,又能抗菌杀虫,保持受精卵的活力,提高受精率和孵化率,抗病性性强,使成活率显著提高;鲫鱼受精卵脱粘剂经冷冻干燥后便于运输和贮藏,使用方便,用量少,节约养殖成本,现将该一种鲫鱼受精卵脱粘剂的制备方法及步骤及实施例介绍如下供研究交流参考:(341241 231292)
技术资料 请支付后查看;1、点击下面"查看详细"按钮提交订单并打开付款码,2、用手机微信扫描付款码完成付款即可查看!!!
200.00元
